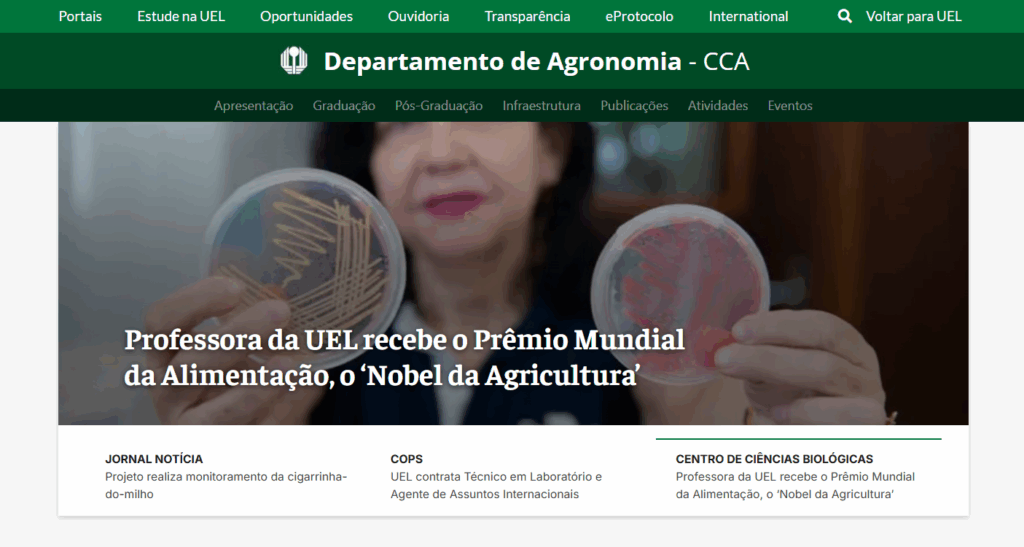

Suporte a Sites
A COM realiza, em parceria com a Assessoria de Tecnologia da Informação (ATI), o processo de repaginação e modernização dos sites da UEL. Os principais objetivos são aprimorar o serviço de hospedagem e gestão dos conteúdos, ofertando um layout institucional padronizado.

Solicitações para o Suporte a Sites:
1- Criar novo site: Solicitar através do e-mail.
O Suporte a Sites e ATI analisarão a necessidade de criação. Se um novo site não for necessário, o Suporte a Sites irá orientar sobre a melhor solução para sua demanda.
2- Treinamento Intensivo: Agende um horário por telefone.
O treinamento ocorre na COM, somente com agendamento prévio.
3- Adaptação ou alteração de site existente: Solicitar por e-mail, descrevendo a adaptação e qual o motivo da alteração.
O Suporte a Sites analisará e, após a aprovação da necessidade, criará a demanda para o usuário.
Observação: O Suporte a Sites realiza treinamentos em grupos, conforme verificada a necessidade. A abertura das turmas de treinamento são anunciadas via e-mail pelo Suporte a Sites, com quantidade restrita de treinandos.